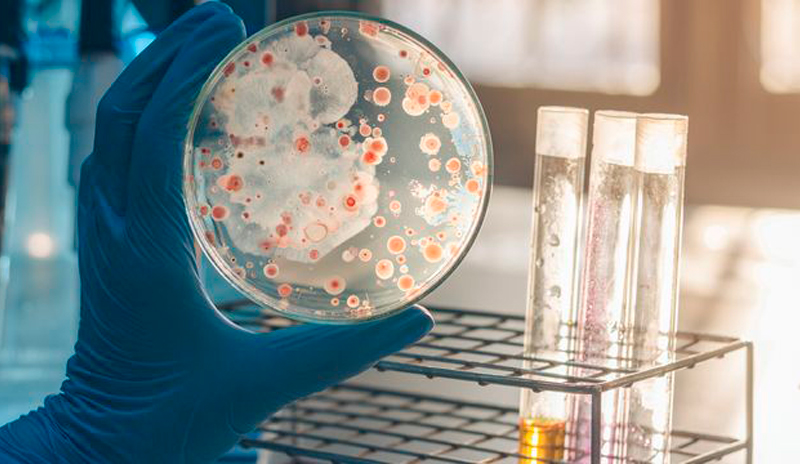
Bacterias observadas en investigación científica

Nuevas investigaciones exploran la relación entre infecciones y deterioro cognitivo
Durante muchos años, el Alzheimer se ha relacionado principalmente con la acumulación de proteínas anormales en el cerebro, como las placas de beta-amiloide y los ovillos de tau. Sin embargo, investigaciones recientes han abierto una nueva línea de estudio: la posible relación entre ciertas bacterias y el desarrollo de esta enfermedad neurodegenerativa.
Aunque todavía se trata de un campo de investigación en desarrollo, algunos científicos consideran que infecciones crónicas podrían influir en los procesos inflamatorios del cerebro y contribuir al deterioro cognitivo.

La hipótesis bacteriana del Alzheimer
En los últimos años, algunos estudios han encontrado evidencia que sugiere que determinadas bacterias podrían participar en los procesos que desencadenan el Alzheimer.
Una de las bacterias que más ha llamado la atención de los investigadores es Porphyromonas gingivalis, asociada a la enfermedad periodontal (infecciones de las encías).
En estudios experimentales se han encontrado:
- Rastros de esta bacteria en el cerebro de personas con Alzheimer
- Toxinas bacterianas llamadas gingipainas, que pueden afectar células cerebrales
- Procesos inflamatorios que podrían acelerar el daño neuronal
Estos hallazgos han llevado a algunos científicos a plantear que las infecciones bucales crónicas podrían estar relacionadas con el riesgo de desarrollar Alzheimer.
Inflamación y salud cerebral
El cerebro es especialmente sensible a los procesos inflamatorios. Cuando el sistema inmunológico responde a infecciones persistentes, puede generar inflamación crónica que afecta las neuronas.
En este contexto, la investigación sugiere que:
- Las bacterias podrían activar respuestas inmunológicas en el cerebro
- La inflamación prolongada podría contribuir al deterioro cognitivo
- La acumulación de proteínas anormales podría ser una respuesta defensiva del organismo
Aun así, es importante aclarar que la hipótesis bacteriana no significa que el Alzheimer sea una infección, sino que las infecciones podrían ser uno de los múltiples factores que influyen en la enfermedad.

La importancia de la prevención y la salud integral
Aunque todavía no existe una cura para el Alzheimer, cada vez hay más evidencia de que la prevención y los hábitos de salud pueden influir en el riesgo de deterioro cognitivo.
Algunas recomendaciones incluyen:
- Mantener una buena higiene bucal
- Controlar enfermedades crónicas como diabetes e hipertensión
- Realizar actividad física regular
- Estimular la mente con actividades cognitivas
- Mantener vínculos sociales activos
Cuidar la salud del cuerpo también ayuda a proteger la salud del cerebro.

💛 Casa Aurora: cuidado especializado en Alzheimer y demencias
En Casa Aurora, residencia geriátrica en Quito, brindamos atención especializada a personas con Alzheimer y otras demencias, con un enfoque integral que incluye estimulación cognitiva, acompañamiento emocional y cuidado profesional.
Nuestro compromiso es ofrecer un entorno seguro, digno y humano para cada residente.
📲 WhatsApp: 0981776117
🌐 www.auroraec.org
Creemos firmemente que envejecer con dignidad significa recibir atención oportuna, comprensión y cariño.
Si desea conocer de qué manera nuestra residencia fomenta la salud mental y atiende de forma personalizada a cada uno de nuestros residentes, lo invitamos a ponerse en contacto con nosotros a través de este enlace.
Topics: casa de retiro
o escríbenos por WhatsApp al 098 177 6117
En Casa Aurora evaluamos el estado mental de los residentes y de las personas mayores que ingresan en nuestro centro. Según las necesidades que detectamos, trabajamos aspectos físicos, sociales o mentales con ellos, de manera individual o grupal.
Para saber más
Desde el alzhéimer precoz o tardío hasta la enfermedad de Parkinson.Se trata de un artículo que explica los diferentes tipos de demencias.
¿Qué es el Deterioro Cognitivo Leve? Diagnóstico del DCL y de la Enfermedad de Alzheimer. Artículo que profundiza en las pérdidas de memoria asociadas a la edad, el deterioro cognitivo leve y las demencias.




